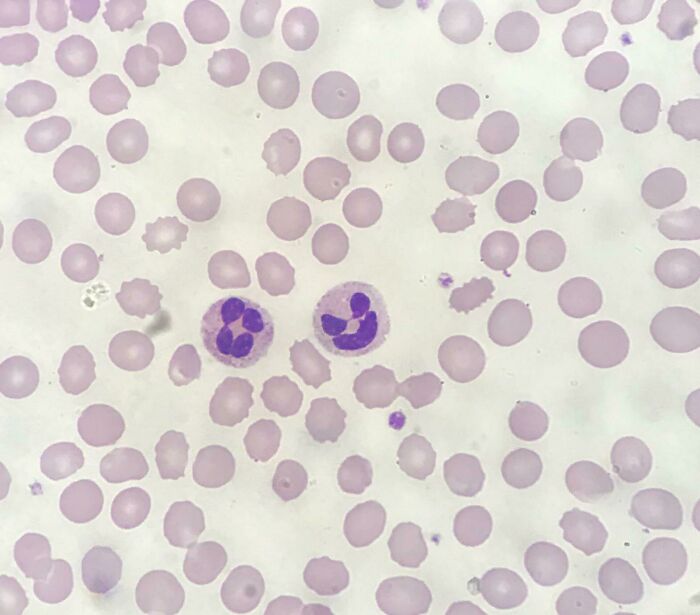
Whoa, These Crazy Close-Up Microscope Pics Will Blow Your Mind

Hey, ready to see stuff so tiny it's like stepping into a secret world? Grab your imaginary lab coat and let's dive into these jaw-dropping microscope photos of things you never knew looked this wild up close.
From pollen looking like alien planets to hair showing off funky textures, these pictures prove that tiny stuff can be totally awesome. Let's check out the hidden universe just below our noses!
This post may include affiliate links.
This 32-40 Million-Year-Old Diatom Skeleton Looks Like Alien Architecture
Check out this dazzling light microscope pic of a tiny algae skeleton that’s been chilling for 32 to 40 million years! These diatoms are like tiny ocean plants with glass-like shells that pile up on the sea floor. It’s nature’s ancient art piece, frozen in time.
Shark Skin Up Close Looks Like Armor from a Sci-Fi Movie
Microscopes are like magic glasses that make tiny things gigantic. They zoom in and make the details pop so we can see a whole secret world hiding in the small stuff.
Sand Grains Zoomed 300x – Tiny Rocky Mountains in Your Sandbox
Chalk Particles Reveal Their Secret Rocky Texture
There are different kinds of microscopes showing different peeks into this mini universe. Some use light, some use electrons, and each way reveals cool but totally different views.
A Cat’s Tongue Is Actually Made of Tiny, Tooth-Like Tongues? Yep!
Wood Up Close Is Like Nature’s Own Abstract Painting
Colors you see in these pictures? Sometimes they’re not real! Scientists add cool dyes or fake colors to help things stand out and look even more amazing.
New Ballpoint Pen Tip Under the Microscope – More Complex Than You’d Think
Meet the Tiny Sea Creatures Swimming in Just a Drop of Seawater
Scientists use special stains to highlight parts of tiny cells or bacteria, so they don’t just look like blobs but colorful little characters with their own stories.
Cancer Cells Look Like a Zombie Apocalypse Under An Electron Microscope
Pollen Clinging to a Horse Fly’s Eyelashes? Weird and Wonderful!
What seems plain and boring suddenly has crazy textures and patterns when zoomed in. A simple surface might turn into the wildest landscape you could imagine.
Whoa, These Crazy Close-Up Microscope Pics Will Blow Your Mind
Whoa, These Crazy Close-Up Microscope Pics Will Blow Your Mind
Zoom in and everyday stuff turns weird and wonderful. Hair shows layers like a bubblegum swirl. Salt looks like sharp, shiny crystals from another planet. And bugs? Their eyes and legs are like tiny machines.
Whoa, These Crazy Close-Up Microscope Pics Will Blow Your Mind
Whoa, These Crazy Close-Up Microscope Pics Will Blow Your Mind
Microscopes aren’t just for fun pictures. They help doctors and scientists figure out what’s going on inside our bodies and in the materials we use every day.
Whoa, These Crazy Close-Up Microscope Pics Will Blow Your Mind
Whoa, These Crazy Close-Up Microscope Pics Will Blow Your Mind
Hospitals use microscopes to spot germs and diseases, while scientists use them to check metals and materials for tiny cracks to keep us safe.
Whoa, These Crazy Close-Up Microscope Pics Will Blow Your Mind
Whoa, These Crazy Close-Up Microscope Pics Will Blow Your Mind
Light microscopes can blow dust and pollen up to a massive size, turning them into otherworldly shapes and glowing colors. It's like nature’s own art show.
Whoa, These Crazy Close-Up Microscope Pics Will Blow Your Mind
Whoa, These Crazy Close-Up Microscope Pics Will Blow Your Mind
Your hair? It has rings and cracks like a tree. Your heart and muscles are patterned mosaics. Even blood cells have cooler shapes than you thought.
Whoa, These Crazy Close-Up Microscope Pics Will Blow Your Mind
Whoa, These Crazy Close-Up Microscope Pics Will Blow Your Mind
Some tiny creatures smaller than a dot have brains, guts, and more. And with the fanciest microscopes, scientists can even see individual atoms. Mind = blown.
Whoa, These Crazy Close-Up Microscope Pics Will Blow Your Mind
Whoa, These Crazy Close-Up Microscope Pics Will Blow Your Mind
At the end of the day, microscopes help us see that even the tiniest things are full of surprises. So next time you look at a grain of salt, remember there’s a whole hidden world in there!

53
0